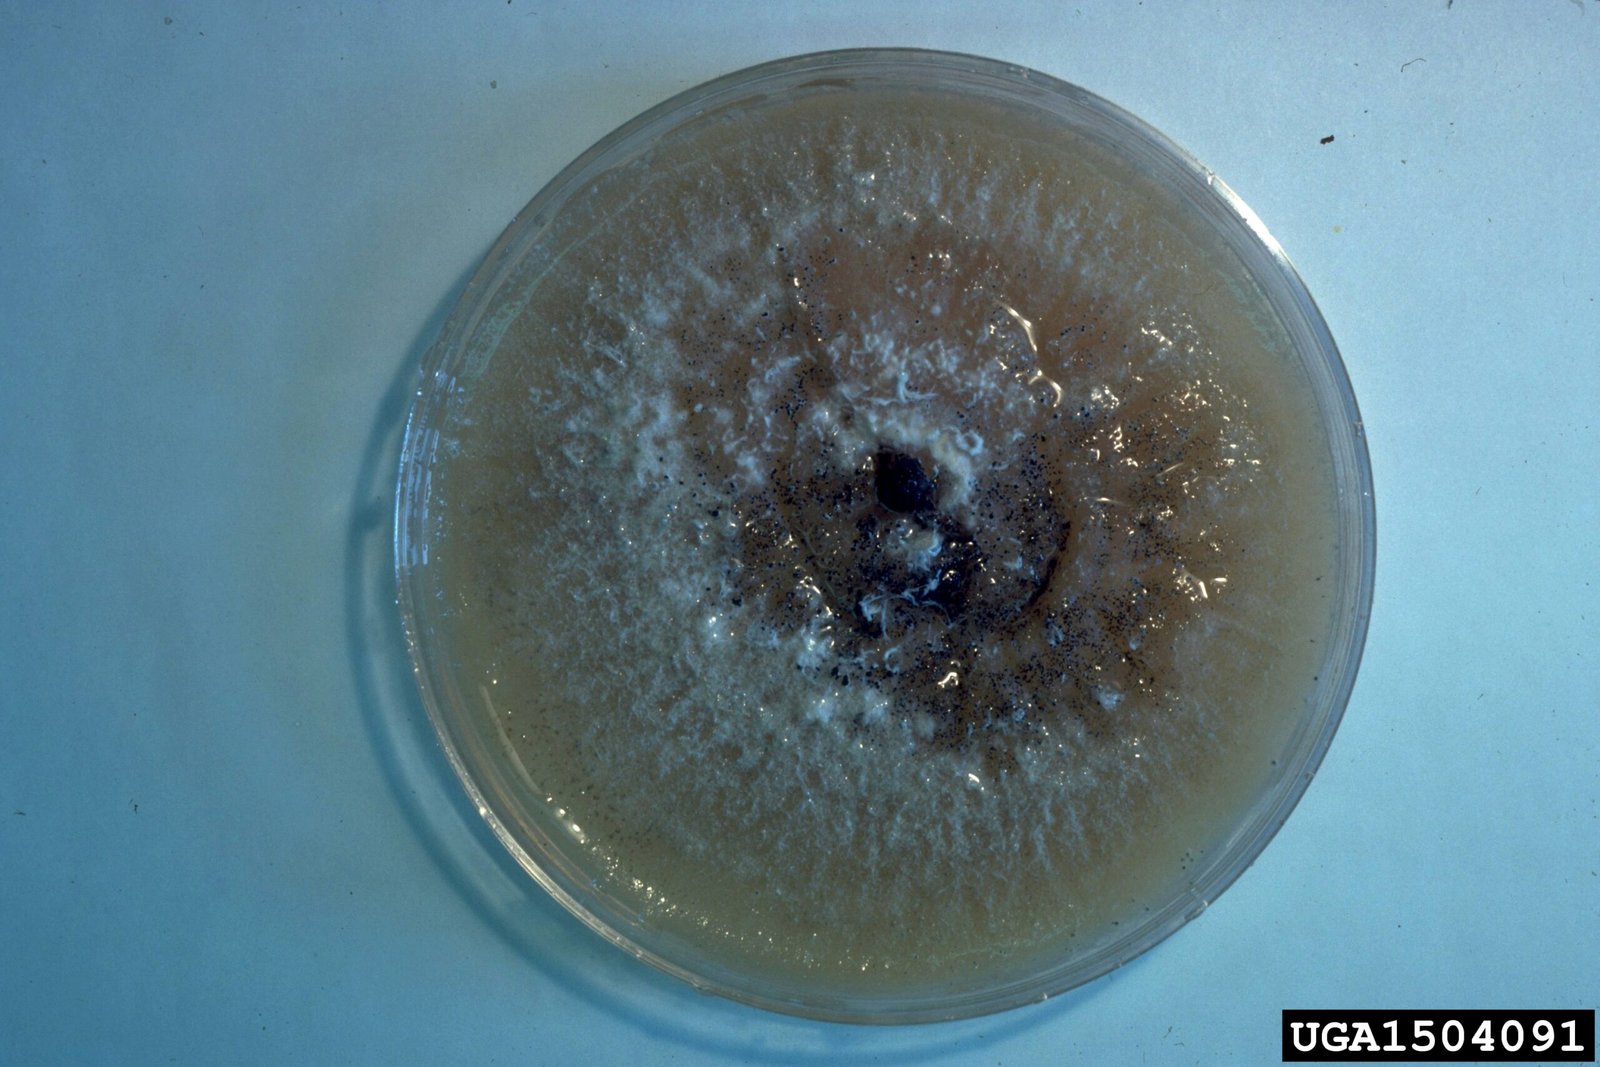
Fungi: The Silent Communicators (image credits: wikimedia)

In the heart of the towering redwood forests, a hidden world exists beneath the roots. This world is not just of soil and stones but one of communication and cooperation. Imagine a secret network where trees converse, share resources, and even warn each other of dangers. This isn’t the plot of a fantasy novel but a reality that’s more astonishing than fiction. How do these giants of nature, standing tall for centuries, manage to communicate without a voice? The answer lies in the intricate and mysterious underground network that binds them together in ways we are only beginning to understand.
The Mystical Mycorrhizal Network

At the core of the redwood forest’s communication system is the mycorrhizal network. This network is a symbiotic association between fungi and tree roots. Think of it as the forest’s very own internet. Just as the internet connects people across the globe, the mycorrhizal network connects trees across the forest floor. Through this network, trees can exchange nutrients, information, and even warnings. It’s a bustling underground world where fungi act as the messengers, facilitating the flow of information between the trees.
Fungi: The Silent Communicators
Fungi are the unsung heroes of the forest. They form a vast network of thin threads called hyphae, which weave through the soil and connect with tree roots. These fungal threads serve as communication channels, transmitting signals and nutrients between trees. In return for their services, fungi receive sugars and other carbohydrates from the trees, creating a mutually beneficial relationship. This partnership is so effective that it can extend across vast distances, linking trees that are hundreds of feet apart.
Resource Sharing: A Forest Economy
In the redwood forest, trees are not just competitors for sunlight and nutrients; they are also collaborators. Through the mycorrhizal network, trees can share resources with one another. For instance, a healthy tree may transfer nutrients to a sick or younger tree, ensuring the survival of the forest as a whole. This resource-sharing system is akin to a forest economy, where trees invest in the well-being of their neighbors, strengthening the entire community.
Warning Signals: The Forest’s Early Warning System
The ability of trees to warn each other of impending danger is one of the most fascinating aspects of their communication network. When a tree is under attack by pests or diseases, it releases chemical signals into the mycorrhizal network. These signals alert neighboring trees, prompting them to bolster their defenses. It’s like an early warning system, where trees act as sentinels, protecting the forest from potential threats.
Mother Trees: The Forest’s Guardians

Among the towering redwoods, certain trees play a crucial role as “mother trees.” These are the largest and oldest trees in the forest, and they act as central hubs in the mycorrhizal network. Mother trees have extensive root systems that connect with numerous other trees, allowing them to distribute resources and information efficiently. They are the guardians of the forest, ensuring that younger trees have the support they need to grow and thrive.
Communication Beyond Words: Chemical Language
Trees may not speak, but they have their own language—one that is chemical. Through the release of volatile organic compounds (VOCs), trees can communicate with each other. These chemicals can convey a range of messages, from distress signals to growth-promoting cues. It’s a complex and nuanced language that allows trees to interact with their environment in ways we are only beginning to comprehend.
The Role of Soil: A Living Medium
The soil in the redwood forest is more than just a medium for plant growth; it is a living ecosystem. It houses countless microorganisms, including bacteria, fungi, and insects, all of which play a role in the forest’s communication network. The soil acts as a conduit, facilitating the transfer of nutrients and signals between trees. It is the foundation of the forest’s underground network, supporting the intricate web of life above.
Implications for Conservation
Understanding the communication network of the redwood forest has profound implications for conservation efforts. Protecting these ancient trees means preserving not just individual organisms but entire ecosystems. By safeguarding the mycorrhizal network and the soil that supports it, we can ensure the survival of the redwood forest and its inhabitants. This knowledge can also inform reforestation efforts, helping us create healthier and more resilient forests for future generations.
The Future of Forest Communication Research

As our understanding of tree communication deepens, new avenues for research and exploration emerge. Scientists are exploring how climate change and human activities impact these networks and what we can do to mitigate these effects. The study of forest communication is a burgeoning field, promising to reveal even more about the hidden lives of trees. As we unlock the secrets of the redwood forest, we gain valuable insights into the interconnectedness of all life on Earth.
A Call to Wonder
The secret underground network of the redwood forest invites us to marvel at the complexity and beauty of nature. It challenges us to reconsider our understanding of trees, not just as solitary giants, but as members of a dynamic and interconnected community. As we stand beneath the towering redwoods, we are reminded of the hidden wonders that lie beneath our feet. What other secrets does the forest hold? What will we discover next?

